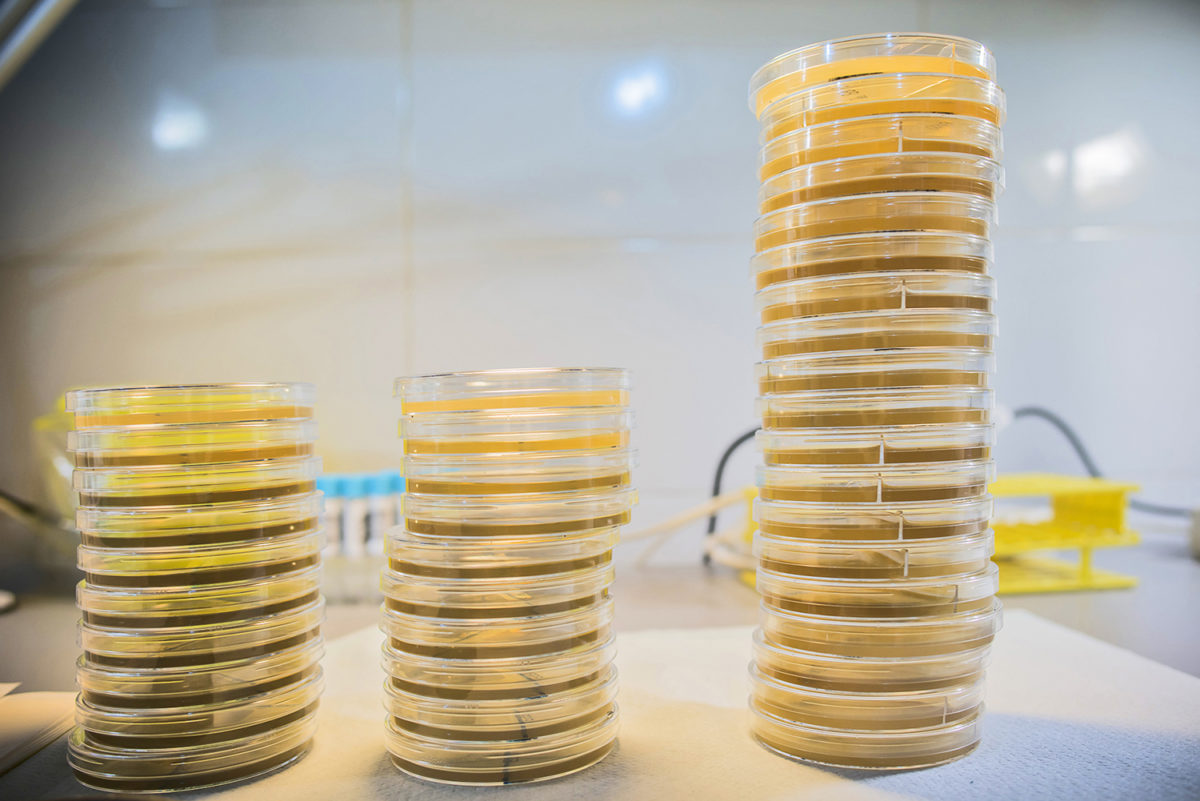
Preclinical studies of the new oral Traveler’s diarrhea vaccine shows that it is safe and immunogenic

Scandinavian Biopharma expanderar för att möta marknadens behov
Ett ökat intresse för våra produkter på den nordiska marknaden resulterar nu i att vi tar steget in och lanserar våra immunglobuliner i Danmark. För att kunna ge våra danska kunder bättre och snabbare service behöver företaget expandera. Scandinavian Biopharma välkomnar nu nyanställda Stefan Einarsson. Stefan har lång erfarenhet från biotech/läkemedelsbranschen både gällande receptbelagda och […]